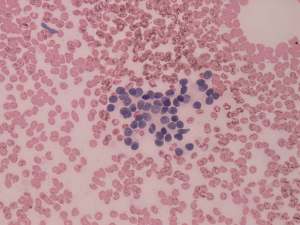

Benign nodular hyperplasia - Case 53. |
|
Clinical presentation: A 33-year-old woman was referred for evaluation of infertility. A minimally elevated TSH was found (4.19 mIU/L).
Palpation: The right lobe was nodular on palpation. Two to three firm lesions were palpable.
Functional state: euthyroidism (TSH 1.05 mIU/L, FT4 17.8 pM/L, aTPO 0 U/mL, anti-hTg 1 U/mL).
Ultrasonography. There were multiple nodules with different echogenicity next to each other in the lower two third of the right lobe. The discrete lesions presented a type perinodular vascularity. The left lobe was intact.
Cytology was performed from the hypoechogenic nodule. Cytological pattern corresponded to a follicular tumor without any atypia.
We gave a combined sonographic-cytological diagnosis of benign follicular proliferation and advised not surgery but regular follow-up investigations.
The essence of follow-up: The patient remained euthyroid in the next two years, i.e. TSH was < 2.0 mIU/L. Two years after the first investigation, the nodular area in the right lobe increased by more than 45% in volume and we advised surgery, i.e. a right lobectomy.
Histopathology disclosed benign hyperplastic nodules.
Comments.
-
Although the presence of halo and type 2 vascular pattern argue for a follicular-type tumor, the multiplicity of discrete lesions is a more significant argument for being these lesions not follicular tumors but non-tumorous, hyperplastic nodules. If we did not consider the sonographic pattern, we had to give a false diagnosis of follicular tumor. This patient took no advantage of follow-up because her nodules later increased in size. Nevertheless, we could give her the chance avoiding surgery.
-
We did not administer replacement therapy if the TSH is only moderately elevated and there is no argument for an underlying autoimmune thyroiditis. In such patients we repeat the TSH and in most cases the elevation spontaneously ceases. The cause for this temporary elevation in TSH is not known but we suggest failure of the laboratory technique.